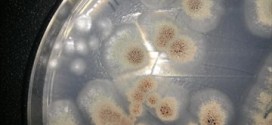
Researchers find Canadian dirt containing Kryptonite for superbugs

Taking regular low doses of aspirin may lower the risk of contracting pancreatic cancer, according to research conducted at Yale University. The study, published in the journal Cancer Epidemiology, Biomarkers & Prevention, surveyed data on 362 people with pancreatic cancer and 690 people without the disease.
Read More »World
Calgary Doctor refuses to prescribe birth control
A Calgary doctor is being criticized by patients for refusing to prescribe birth control at a walk-in clinic. When Dr. Chantal Barry is on shift a sign at the WestGlen Medical Centre informs patients that the doctor on duty does not prescribe birth control pills.
Read More »Live-in nanny fired, but refuses to leave (Video)
They were the all-American family looking for help with their three young children. Upland couple Marcella and Ralph Bracamonte posted an ad on Craigslist seeking a nanny in exchange for room and board. Instead, they got Diane Stretton, who at first pretended to be their nanny, but is now squatting in their home. The couple said they called Stretton’s references …
Read More »Princess Theodora Sayn-Wittgenstein fined for violent, drunken, anti-Muslim rant
A German princess was arrested after stripping off her clothes and racially abusing a first aider at a posh university party – and was even put in leg restraints by police due to her aggressive behaviour.
Read More »Ireland Baldwin Shows Off Cute Pic With Girlfriend Angel Haze (Photo)
Ireland Baldwin, 18, is the daughter of famous actors Kim Basinger and Alec Baldwin, but now the model is officially confirming her months-long relationship with rapper Angel Haze, 22.
Read More »Shia Labeouf arrested for disorderly conduct (Video)
Actor Shia LaBeouf was arrested Thursday for being disorderly inside New York’s Studio 54 during a musical performance of “Cabaret,” media reports said, citing police. The 28-year-old actor was reportedly handcuffed and taken out of the Broadway theatre as he was “disruptive during Act 1,” of the Tony-nominated play, which stars Michelle Williams and Alan Cumming.
Read More »US : FDA gives advice on teething children
The U.S. Food and Drug Administration warned yesterday against using a lidocaine solution as a pain reliever on teething babies’ gums, saying it can cause deaths and serious injuries in infants and toddlers.
Read More »Fruits and vegetables don’t lead to weight loss, Study
Eating fruits and veggies is good for your health, but eating more of them won’t necessarily have any effect on weight loss, says a new study from the Univ. of Ala. at Birmingham. The recommended daily serving amount for adults is 1.5-2 cups of fruit and 2-3 cups of vegetables, says the United States Department of Agriculture’s MyPlate initiative.
Read More »Kim Kardashian : Reality television star Gets Nose Job To Look Like Charlize
Reality television star Kim Kardashian can’t avoid plastic surgery rumors despite having Kanye West for her husband as new gossip claims she had work done to her nose.
Read More »Researchers find Canadian dirt containing Kryptonite for superbugs
McMaster scientists are taking aim at “public enemy No. 1.” They have found a fungus in the soils of Nova Scotia that offers new hope in the battle against drug-resistant germs, which kill tens of thousands of people every year.
Read More »Tiger snatches man off fishing boat in India (Video)
An Indian fisherman says a tiger has snatched his father off a fishing boat and dragged him away into a mangrove swamp. Jyotish Majhi says he was fishing for crabs with his father and sister Thursday when the tiger leaped onto their boat. He says he and his sister beat the tiger with sticks, but their 60-year-old father was still …
Read More » Canada Journal – News of the World Articles and videos to bring you the biggest Canadian news stories from across the country every day
Canada Journal – News of the World Articles and videos to bring you the biggest Canadian news stories from across the country every day